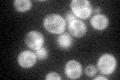
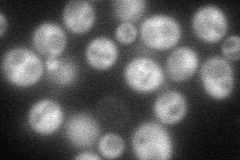
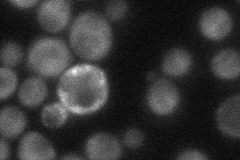
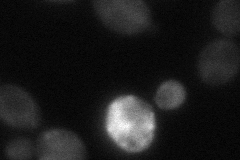
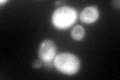
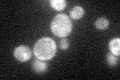

View description
Sensor of mitochondrial dysfunction; regulates the subcellular location of Rtg1p and Rtg3p, transcriptional activators of the retrograde (RTG) and TOR pathways; Rtg2p is inhibited by the phosphorylated form of Mks1p
Localization:
Intensity:
Fold change:
Significance:
-
C’ GFP library in SD
cytosol53.11 -
N' NOP1pr-GFP in SD
cytosol97.7699 -
N' TEF2pr-mCherry in SD

cytosol97.3711 -
N' NATIVEpr-GFP in SD
cytosol28.7085 -
N' TEF2pr-VC and Cyto-VN in SD
cytosol30.9102 -
C’ GFP library in SD+DTT
cytosol64.781.21No -
C’ GFP library in SD+H2O2

cytosol55.911.05No -
C’ GFP library in Starvation Media
cytosol58.051.09No -
C’ GFP library on the background of Pup2-DaMP

cytosol -
C’ GFP library on the background of CCT mutant

cytosol53.51311.0075No
